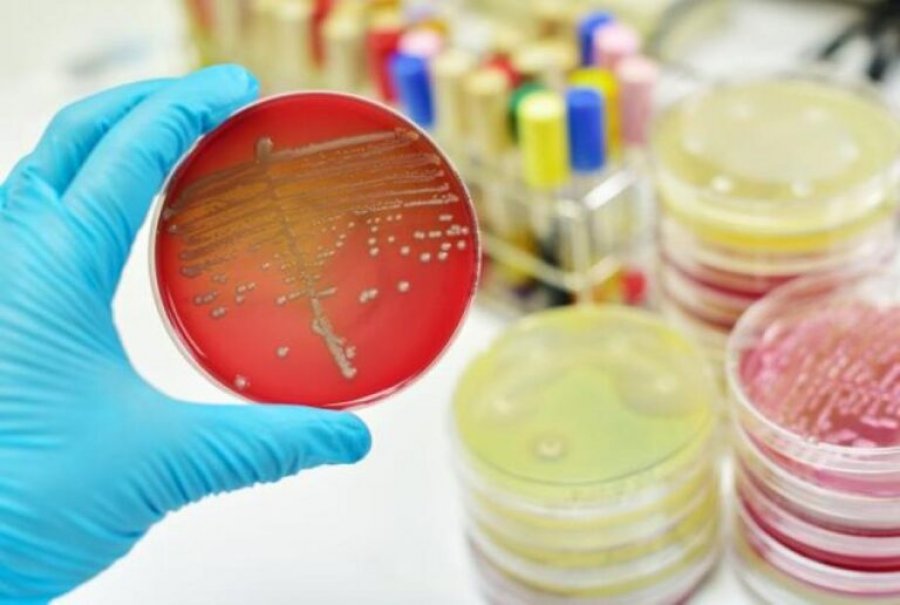
Bakteret ushqimore si Salmonella dhe Kampilobakteri, po bëhen rezistente ndaj antibiotikëve në Evropë

Bakteret ushqimore si Salmonella dhe Kampilobakteri, po bëhen rezistente ndaj antibiotikëve në Evropë
Rezistenca antimikrobiale (AMR) në bakteret ushqimore mbetet një shqetësim serioz për shëndetin publik në Evropë, duke kufizuar opsionet e trajtimit, paralajmërojnë agjencitë europiane.
Bakteret më të zakonshme që shkaktojnë sëmundje ushqimore, si Salmonella dhe Kampilobakteri, tregojnë nivele të larta rezistence ndaj antibiotikëve të rëndësishëm, përfshirë ciprofloksacinën.
Raporti i fundit i Qendrës Europiane për Parandalimin dhe Kontrollin e Sëmundjeve (ECDC) dhe Autoritetit Europian të Sigurisë Ushqimore (EFSA) zbuloi se mbi një në pesë infeksione njerëzore me Salmonella në 2024 nuk i përgjigjej ciprofloksacinës, raporton Euronews Health transmeton Gazeta Shneta.
Në rastin e Kampilobakteri, ciprofloksacina nuk rekomandohet më si trajtim për infeksionet njerëzore.
Këto baktere gjithashtu tregojnë rezistencë ndaj antibiotikëve të tjerë të përdorur zakonisht, si ampicilina, tetraciklinat dhe sulfonamidët.
Piotr Kramarz, shkencëtar kryesor në ECDC, theksoi se rezistenca antimikrobiale tregon lidhjen e ngushtë mes shëndetit të njeriut, kafshëve dhe ushqimit, dhe kërkon veprim të koordinuar sipas qasjes “One Health”, e cila njeh lidhjen ndërmjet shëndetit të njerëzve, kafshëve, bimëve dhe mjedisit.
Modelet e rezistencës ndryshojnë mes vendeve dhe baktereve, duke reflektuar praktikat e ndryshme të përdorimit të antibiotikëve, masat shëndetësore për kafshët dhe strategjitë parandaluese.
Në 2024, Bashkimi Europian raportoi 168,396 raste njerëzore me Kampilobakter dhe 79,703 raste me Salmonella, me një rritje të vazhdueshme që nga 2020.
Rritja e infeksioneve ushqimore lidhet me zakonet e ndryshuara të të ushqyerit, përfshirë ushqimet e gatshme, praktikat jo higjenike të trajtimit të ushqimit dhe plakjen e popullsisë që e bën atë më të ndjeshme ndaj sëmundjeve.
Rezistenca antimikrobiale në ushqime është një kërcënim i përhapur që kërkon masa të koordinuara në nivel kombëtar dhe europian për të mbrojtur shëndetin publik dhe efektivitetin e trajtimeve antibiotike.

